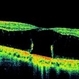

File number: 132918
Comments
-
 Daniel Davis, OCT-C (May 20 2025)
Daniel Davis, OCT-C (May 20 2025)Great myopic OCT!
-
Manish Nagpal, MD, FRCS (UK), FASRS (April 5 2025)
fantastic capture
Sign in to comment.
-
 By Drew Mitchell
By Drew Mitchell
Retina Associates LLC - Uploaded on Mar 17, 2025.
- Last modified by Joshua Friedman on May 1, 2025.
- Image of the week
-
May 4, 2025
View all images of the week - Rating
- Appears in
- OCT Collection
- Condition/keywords
- Macular hole, full thickness macular hole, myopic foveoschisis, PVD, myopic traction maculopathy, myopic macular schisis
- Photographer
- Drew Mitchell OCT-C
- Imaging device
-
Optical coherence tomography system
Zeiss Cirrus 5000 - Description
- HD 1 line 100x 9 mm scan of a right eye with MTM at stage 3c. Macular Schisis Detachment.

 Initializing download.
Initializing download.---thumb.jpg/image-square;max$79,0.ImageHandler)
---thumb.jpg/image-square;max$79,0.ImageHandler)